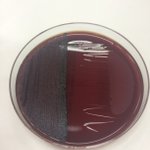

@fractalbears and here we go with the good old "conditioner and brush" trick

zittrain Or as some would call it, "taxes." pic.twitter.com/DOVGN4OUNC

mraleph I would not recommend sending kisses emoji to people with Firefox OS pic.twitter.com/n0hxU3P1cN
@fractalbears I totally would
TW3000!
RT @martindelius: 1Mio Geflüchtete in einem Jahr und keinem geht es schlechter. Nichteinmal den meisten Geflüchteten auch wenn es denen noc…
RT @martindelius: Wir sind so wenig überfordert, dass wir ohne Probleme mehr tun könnten, damit es den Geflüchteten besser geht. Das ist da…
RT @martindelius: Aber wenn jeder Politiker mal in der Zeitung sagen darf, dass wir überfordert sind, wird es wohl stimmen.

haruhoweIl look at the card my mum just played holy shit this is too real pic.twitter.com/LsVWBMXDF3
RT @herrurbach: DU MUSST MIR SCHON ERKLÄREN WAS EIN RASSIST IST! https://t.co/1seBO869VO
Kchrchrchrch ðŸ˜

Miffy_UK What else can you think of that begins with F? #MiffyABC pic.twitter.com/8tKNsw6MBw
AstroKatie If you're worried someone might accuse you of harassment, just be really careful not to harass anyone. Lots of resources online with tips.
RT @GoaGoaZwerg: Polizisten urinierten bei #Rigaer-Razzia in Wohnungen, beschmieren Wände mit Parolen gegen "Zecken", malen Penisse. https…

BitchMedia Good advice for Stephen Colbert (and all other white people) on addressing privilege: bit.ly/1WsCTdt pic.twitter.com/WZjEGhTsPp
DaddyOhnePlan Chef zur Kollegin: "Sie haben das Hirn zwischen den Beinen."
Heute rief sie an:
"Chef, kann nicht kommen, hab Hirnblutung."
Made my Day!
"Bei der Kloake, die wir Mundhöhle nennen."#mikrobiologiee
Dieser Dozent ist episch gut.
Gespräch mit dem#mikrobiologiee-Tutor.
"Was spricht gegen eine Impfpflicht?"
"Nur die Impfgegner."
Recht hat er.
RT @feminizza: Do you think bi/pan/polysexual women who date men are still part of the LGBT* community?
(pls RT after u voted)
@feminizza yes, yes and yes. And it's sad that this is not clear to everyone.. :( (the "B" is not for "bees".)
Heute: Blutkulturen, Diphterie (Foto), Sporenbildner (Anthrax und Clostridien) und Tuberkulose. pic.twitter.com/qIPo2XTrOo
fractalbears They do also want us working 10 hours a week too. Presumably a workfare style of thing because no one's going to hire people like me.
fractalbears This covers what IDS is planning for PIP and ESA, where extreme psychological distress/mental illness is not going to be counted as much etc
RT @fractalbears: Mental health, poverty, and the erosion of the social safety net. https://t.co/lRUlDSL2Qr #ImNotAshamed #ESA #PIP #WOWpet…
Bediko Wenn Schnee liegt nicht raus gehen, DAS SIND GEFRORENE CHEMTRAILS!!!11!1

LightheartedDan Guess who didn't learn from Black Widow? pic.twitter.com/yOidwpg5GN
DanielaKayB "This is the sound a chicken makes when it sneezes. That is all...move along." vine.co/v/OOxhPqhTvwZ
RT @Med_Nerdette: The People Who Brought You “Period Underwear†Now Have a Line for Men Who Menstruate - thecorpsekid:... https://t.co/O8Il…
Aber das wird natürlich nicht gesehen.
To be totally honest: deren Probleme wären wesentlich größer OHNE Kita-Erzieher*innen.
RT @queer_de: Studie: Jeder fünfte Deutsche hat Probleme mit schwulen Kita-Betreuern. https://t.co/geJPRim6EB https://t.co/u6yzzGJjzA
@malde nur durch die Musik.
RT @FlorianFlade: Flughafen #Genf entlässt 30 muslimische Mitarbeiter aufgrund von Sicherheitsbedenken @welt https://t.co/WSUwKTrkbG #Schwe…
RT @amina_you: Plötzlich spricht der Mensch mir gegenüber mich an und fragt ob ich Schnee kenne, & ob es Schnee da wo ich herkomme überhaup…
RT @amina_you: Gestern war ich mit einer Freundin in Hannover in der Straßenbahn unterwegs&wir unterhielten uns über den Schnee der gerade …

BlvckConscious 16 y/o #GynnyaMcMillen was found dead at a detention center and her autopsy reads there's "no cause of death". pic.twitter.com/n0esrbgOqm
RT @Grumpfdalm: "Aber wenn man die richtige Kinderkrankheit durchmacht, kann das Immunsystem besser dran wachsen!"
Nein. https://t.co/e94y…
RT @feenzeit: Ich verkaufe mein MacBook Pro 13" (Anfang 2011), 2.3GHz, 16GB RAM, 240 GB SSD. https://t.co/11rAYMmdzP
@DanielaKayB yay, jede Menge Spam pop-up Werbung